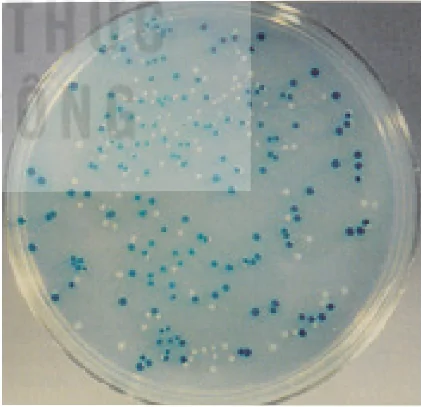

Nội Dung Chính
Trang 19
YÊU CẦU CẦN ĐẠT
• Dựa vào sơ đồ, mô tả được các bước trong công nghệ gene.
• Giải thích được cơ sở khoa học chuyển gene và vì sao phải sử dụng vector để truyền gene từ tế bào này sang tế bào khác.
• Trình bày được các bước tạo thực vật chuyển gene và tạo động vật chuyển gene. Lấy được ví dụ minh hoạ.
| MỞ ĐẦU Chuyển gene loài này sang loài khác nhằm mục đích gì? |
I. KHÁI NIỆM VÀ QUY TRÌNH CÔNG NGHỆ GENE
1. Khái niệm
Công nghệ gene là quy trình công nghệ sử dụng các kĩ thuật DNA tái tổ hợp để thay đổi kiểu gene và kiểu hình của sinh vật. Ứng dụng công nghệ gene vào thực tiễn được gọi là công nghệ sinh học.
Nguyên lí của công nghệ gene có thể tóm tắt như sau: Tách gene cần chuyển (gene chuyển) ra khỏi tế bào cho rồi dùng kĩ thuật PCR tạo ra nhiều bản sao. Đồng thời tách DNA dùng làm vector ra khỏi tế bào. Sau đó xử lí gene chuyển và vector bằng cùng một loại enzyme cắt giới hạn và trộn các loại phân tử này với nhau cùng với enzymte ligase để tạo ra DNA tái tổ hợp. DNA tái tổ hợp được truyền vào tế bào nhận để tạo ra tế bào chuyển gene.
Sản phẩm của công nghệ gene là các protein của gene chuyển được tạo ra trong tế bào nhận, có thể được sử dụng làm thuốc chữa bệnh hoặc cho các mục đích khác nhau. Ví dụ: Gene của người có thể chuyển vào vi khuẩn, vì vi khuẩn sinh sản nhanh nên lượng sản phẩm của gene người nhanh chóng được tạo ra trong các tế bào vi khuẩn với số lượng lớn. Gene chuyển cũng có thể được nhân bản thành nhiều bản sao trong tế bào vi khuẩn và sau đó được tách chiết dùng cho mục đích nghiên cứu cấu trúc, chức năng của gene hoặc các mục đích ứng dụng thực tiễn. Sản phẩm của công nghệ gene còn có thể là các tế bào thực vật chuyển gene được nuôi cấy tái sinh thành các cây biến đổi gene. Đối với động vật, từ hợp tử chuyển gen có thể cho ra các con vật biến đổi gene.
5. Quy trình công nghệ gene
Quy trình công nghệ gene rất phức tạp nhưng có thể tóm tắt qua ba bước như minh hoạ ở Hình 3.1.
Bước 1: Phân lập gene chuyển
Gene chuyển hay gene đích là gene cần chuyển từ sinh vật này sang sinh vật khác, Trước hết, gene chuyển phải được phân lặp ra khỏi hệ gene của tế bào cho gene, sau đó, bằng các kĩ thuật khác nhau mà gene chuyển được nhân bản tạo ra các bản sao giống hệt nhau (thường dùng kĩ thuật PCR). Nếu gene chuyển lấy từ tế bào nhân thực với mục đích chuyển
Trang 20
vào tế bào nhân sơ thì trước khi gắn vào vector, gene chuyển cần phải được loại bỏ các intron. Để làm được điều này, người ta thường phân lập gene chuyển bằng cách phân lập mRNA trưởng thành của gene chuyển (không còn các intron), sau để cho phiên mã ngược thành cDNA.
Bước 2: Cài gene cần chuyển vào vector
Gene đích được cài vào vetor (thể truyền) để thu được DNA tái tổ hợp. Tuỳ theo mục đích của công nghệ gene và đối tượng nghiên cứu mà người ta có thể sử dụng các loại vector khác nhau. Ví dụ: Muốn chuyển gene của người vào tế bào vi khuẩn để gene có thể phiên mã và dịch mã trong tế bào vi khuẩn, các nhà khoa học thường chọn vector là pIasmid. Plasmid có nguồn gốc từ vi khuẩn nên chúng có thể dễ dàng biến nạp vào tế bào vi KT khuẩn và có thể tạo ra nhiều bản sao dẫn đến gene chuyển cũng có được nhiều bản sao trong cùng một tế bào, từ đó tạo ra nhiều sản phẩm. Để gene của người có thể phiên mã và dịch mã được trong tế bào vi khuẩn thì gene chuyển lấy từ người không những phải được loại bỏ intron và các trình tự điều hoà bằng cách sử dụng cDNA như đã nói ở trên mà còn phải được gắn vào vùng điều hoà của một gene nằm trong vector (plasmid) của vi khuẩn. Có như vậy, bộ máy phân tử của tế bào vi khuẩn mới có khả năng phiên mã và dịch mã gene của người.
Nếu muốn chuyển gene vào tế bào động vật và thực vật, các nhà khoa học thường sử dụng vector là các loại virus vốn sống trong các tế bào động, thực vật và có khả năng tích hợp hệ gene của chúng vào hệ gene của tế bào động, thực vật. Nhờ vậy, gene chuyển mới có thể gắn được vào nhiễm sắc thể của tế bào động, thực vật và hoạt động bình thường.
Để cài gene chuyển vào vector các nhà khoa học phải sử dụng cùng một loại enzyme cắt giới hạn khi cắt gene chuyển và vector để tạo ra cùng loại đầu dính. Sau khi cắt bằng enzyme cắt giới hạn, các đoạn DNA từ hai nguồn được trộn với nhau và sử dụng enzyme ligase để gắn chúng với nhau tạo ra DNA tái tổ hợp.

Hình 3.1. Các bước của một quy trình công nghệ gene cơ bản
Trong sơ đồ giản lược trên, chỉ có một plasmid được phân lập từ vi khuẩn (làm vector) và một gene chuyển, nhưng trong thực tế, vật liệu khởi đầu thường gồm nhiều bản sao của mỗi phân tử này
Phân lập gene chuyển: Sử dụng enzyme giới hạn hoặc PCR để phân lập đoạn DNA mang gene chuyển.
DNA mang gene chuyển (Ví dụ: insulin người)
Cài gene cần chuyển vào vector
Vi khuẩn
NST vi khuẩn
Plasmid
Gene chuyển
Vector DNA (plasmid) tái tổ hợp
Chuyển vector vào tế bào nhận
Vi khuẩn tái tổ hợp
Nhân dòng gene: Tế bào được nuôi để tạo một dòng các tế bào mang gene chuyển.
Bản sao của gene chuyển
Protein của gene chuyển
Nghiên cứu cơ bản và ứng dụng thực tiễn khác nhau của gene chuyển và protein của gene chuyển.
Trang 21
Bước 3: Chuyển vector vào tế bào nhận
Vetor tái tổ hợp được chuyển vào tế bào nhận bằng nhiều cách khác nhau. Các vector là plasmid hoặc virus có thể tự biến nạp và tải nạp vào tế bào. Một số trường hợp phải dùng kim tiêm hoặc súng bắn gene để đưa DNA tái tổ hợp vào tế bào.
| DỪNG LẠI VÀ SUY NGẪM Hãy vẽ sơ đồ phác thảo ba bước của một quy trình công nghệ gene cơ bản. Lấy ví dụ về nhân dòng và biểu hiện một gene của người (như gene quy định hormone sinh trưởng HGH) trong tế bào vi khuẩn E.coli. Mục đích chuyển gene HGH của người vào tế bào vi khuẩn là gì? |
II. CƠ SỞ KHOA HỌC CÙA CHUYỂN GENE
1. Vai trò của vector
Khi một đoạn DNA ngoại lai xâm nhập vào bên trong tế bào thì hệ thống enzyme của tế bào sẽ phân huỷ giống như cơ chế miễn dịch ở người chống lại các tác nhân bên ngoài xâm nhập vào cơ thể. Muốn gene chuyển vào tế bào có thể tồn tại, tái bản và phiên mã, dịch mã được thì gene phải được cài vào hệ gene của tế bào chủ hoặc ở trong một cấu trúc cho phép gene tồn tại, nhân bản, phiên mã và dịch mã bình thường được gọi vector.
2. Đặc điểm của vector
Tất cả các veor đều có ba đặc điểm chung về cấu tạo (thuộc tính phân tử):
- Có một trình khởi đầu tái bản: Trình tự này được bộ máy tái bản của tế bào chủ nhận biết, chẳng hạn như trình tự Ori ở E.coli hay ARS ở nấm men, nhờ vậy vector được tái bản mỗi khi được chuyển vào tế bào chủ.
- Có một (hoặc một số) gene chỉ thị chọn lọc: Gene này biểu hiện như một gene trội, nhờ đó, nó có thể giúp phân biệt được tế bào mang vector với các tế bào không mang vector. Ở vi khuẩn trong các gene chỉ thị chọn lọc phổ biển có các gene kháng chất kháng sinh như gene ampR kháng ampicllin, gene tetR kháng tetracycline . Ở nấm men có các gene phục hồi khuyết dưỡng như gene Leu+ (tổng hợp amino acid leucine) hay gene Ura+ (tổng hợp uracil). Khi các vector mang các gene chỉ thị chọn lọc được chuyển vào các tế bào nhận vốn không có khả năng kháng kháng sinh hoặc khuyết dưỡng thì chỉ các tế bào chứa vector mới có thể sống được trong môi trường có chất kháng sinh hoặc thiếu chất dinh dưỡng. Ở cơ thể đa bào (như vật nuôi và cây trồng), một nhóm gene chỉ thị chọn lọc được ưa dùng là các gene phát huỳnh quang (dưới ánh sáng UV) hoặc phát sáng trong tối, như gene GFP (protein phát huỳnh quang lục) được phân lập từ sứa hay gene phát sáng được phân lập từ đom đóm. Lúc này các, cơ thể chuyển gene thành công (mang vector sẽ dễ dàng được nhận biết khi quan sát dưới đèn UV (với gene GFP) hoặc trong tối tvới gene phát sáng từ đom đóm).
- Có vị trí nhân dòng: Đây là điểm để cài các đoạn DNA ngoại lai vào vector. Về bản chất, nó là một đoạn trình tự DNA ngắn trên vector, chứa một số vị trí giới hạn đặc thủ, Thường thì mỗi vetor chỉ có một vị trí giới hạn duy nhất đối với một loại enzyme giới hạn nhất định, nhưng nó đồng thời có nhiều vị trí giới hạn tương ứng với các enzyme giới hạn khác nhau. Trong quy trình công nghệ gene cơ bản nhất, vector được cắt tại vị trí giới hạn duy nhất của nó bằng enzyme giới hạn phù hợp, rồi cài vào vị trí đó đoạn DNA ngoại lai cũng được cắt bởi cùng loại enzyme giới hạn.
Trang 22
Đến nay đã có nhiều loại vector được phát triển, bao gồm: các vector plasmid (có nguồn gốc vi khuẩn) (H 3.2), các vector virus (có nguồn gốc virus như phage λ), cosmid (vector lai có cả thuộc tính của plasmid và vector virus), vector plasmid Ti (dùng để nhân dòng và chuyển gene ở thực vật) và các nhiễm sắc thể nhân tạo (có nguồn gốc nấm men). Các loại vector khác biệt nhau về một số thuộc tính phân tử, loại tế bào chủ (thể nhận gene) và kích thước tối đa các đoạn DNA đích mà chúng có thể nhân dòng. Tùy thuộc vào kích thước đoạn DNA đích và loại tế bào chủ mà người ta chọn loại vector phù hợp.

Hình 3.2. Ảnh hiển vi điện tử NST và plasmid của vi khuẩn
(Plasmid là những phân tử DNA vòng nhỏ, là nhiễm sắc thể của vi khuẩn vòng lớn)
Hình 3.3. Minh họa một vector có nguồn gốc từ plasmid của E. coli và vector pUC19. Vector này dài 2686 bp và có một số đặc điểm giúp nó nhân dòng gene hiệu quả ở E. coli như có thể được tái bản tới 100 bản sao trong mỗi tế bào (nhờ vậy hiệu suất nhân dòng cao), mang gene chỉ thị chọn lọc ampᴿ và chứa một vùng mang nhiều vị trí giới hạn của các enzyme giới hạn khác nhau (trên hình biểu thị 11 vị trí giới hạn) gọi là vị trí đa nhân dòng (MCS).

Hình 3.3. Vector nhân dòng plasmid pUC19
(ori = trình tự khởi đầu tái bản, ampᴿ = gene chỉ thị chọn lọc kháng kháng sinh ampicilin, lacZ+ = gene chỉ thị chọn lọc mã hóa β - galactosidase)
Vị trí đa nhân dòng (MSC, polylinker)
Điểm khởi đầu sao chép
Vị trí MCS được thiết kế thành một phần của gene LacZ+ mã hóa enzyme β - galactosidase của E. coli. Trong tự nhiên, enzyme này chuyển hóa lactose thành galactose và glucose. Tuy vậy, trong điều kiện in vitro, enzyme này còn có hoạt tính xúc tác chuyển hóa một cơ chất không màu tên là X-gal thành một hợp chất có màu xanh tím có tên là 5 - bromo - 4 - chloro - in - digo. Nhờ vậy, có thể phân biệt được vi khuẩn mang vector (chứa DNA cài gắn vào vị trí MCS và phá vỡ gene LacZ+; có khuẩn lạc màu trắng) với các vi khuẩn không mang vector tái tổ hợp (gene LacZ+ còn nguyên vẹn, β - galactosidase được biểu hiện vi khuẩn lạc có màu xanh tím) khi trong môi trường có X-gal. Kĩ thuật này được gọi là sàng lọc khuẩn lạc xanh – trắng (H 3.4).
Hình 3.4. Phương pháp chọn lọc khuẩn lạc xanh – trắng khi sử dụng vector pUC19
Các khuẩn lạc mọc trên môi trường chứa ampicilin là các khuẩn lạc chứa vector (nhờ có gene ampᴿ); các khuẩn lạc xanh không mang gene cài nên gene LacZ+ còn nguyên vẹn (enzyme này chuyển hóa X-gal thành chất có màu xanh). Các khuẩn lạc trắng gồm các tế bào mang gene đích đã được cài vào vector.
Trang 23
3. Tạo vector tái tổ hợp
Gene chuyển và vector mang gene phải được sử bằng cùng một loại enzyrne cắt giới hạn để có cùng loại đầu dính có thể liên kết được với nhau theo nguyên tắc bắt đôi bổ sung. Liên kết phosphodlester được hình thành giữa các đoạn DNA nhờ enzyme ligase. Hình 3.5 minh hoạ phương pháp cài đoạn DNA đích vào vector trong trường hợp này là vector pUC19.

Hình 3.3. Phương pháp cài đoạn DNA đích vào vetor
Vị trí cắt của enzyme giới hạn
Vector pUC19 trước khi cài gene chuyển quy định tính kháng ampicillin và biểu hiện β – galactosidase ở vi khuẩn
Enzyme giới hạn
Vector sau khi được xử lí với enzyme giới hạn
DNA ligase
Các đoạn DNA cài
DNA cài làm hỏng gene LacZ+
Vector tái tổ hợp quy định tính kháng ampicillin nhưng không biểu hiện β – galactosidase ở vi khuẩn
DỪNG LẠI VÀ SUY NGẪM
1. Nêu cai trò của vector trong công nghệ gene.
2. Tại sao vector cần có ba thành phần (thuộc tính phân tử): trình tự khởi đầu tái bản, gene chỉ thị chọn lọc và vị trí nhân dòng?
II. CHUYỂN GENE Ở THỰC VẬT VÀ ĐỘNG VẬT
1. Chuyển gene ở thực vật
Một trong các phương pháp chuyển gene có hiệu quả cao ở cây trồng được nhà vi sinh vật Mary Dell Chilon phát triển năm 1983, cho phép cài gene ngoại lai trực tiếp vào
nhiễm sắc thể của nhiều loại cây trồng. Phương pháp này sử dụng vi khuẩn Agrobacterium tumefaciens vốn sống cộng sinh và gây nốt sần ở các loài cây họ Đậu. Vi khuẩn này chứa
một loại plasmid mang gene gây nốt sần (khối u) gọi là plasmid Ti (tumor inducing). Ngoài các gene gây khối u (gene bệnh), plasmid Ti còn mang các gene mã hoá cho một số protein có vai trò chuyến một đoạn DNA của nó (go là đoạn T-DNA) vào trong tế bào thực vật và cài T-DNA này vào hệ gene của thực vật. Chilton đã cải tiến plasmid Ti bằng
cách loại bỏ các gene bệnh (vốn không cần cho quá trình chuyển T-DNA) và cài vào T-DNA của plasmid Ti đoạn trình tự gene mong muốn (ví dụ như gene mã hoá protein độc tố kháng sâu Bt từ vi khuẩn Bacillus thurigiensis). Lúc này, các vi khuẩn A.tumefaciens mang plasmid Ti tái tổ hợp có thể chuyển và cài gene mong muốn vào cây trồng khi hạt giống, cây non hoặc tế bào nuôi cấy in vitro được ủ với vi khuẩn mang plasmid Ti tái tổ hợp. Hình 3.6 biểu thị các bước chuyển gene ở thực vật nhờ vi khuẩn A.tumefaciens.
Trang 24

Hình 3.6. Các bước chuyển gene ở cây trồng sử dụng vector plasmid Ti và vi khuẩn Agrobacterium tumefaciens
Vi khuẩn Agrobacterium tumefaciens
Phân lập plasmid
Vị trí giới hạn
T-DNA
Plasmid Ti
Đoạn DNA chứa gene đích
Enzyme giới hạn và DNA ligase
Vector tái tổ hợp
Chuyển vector vào A. tumefaciens và sàng lọc vi khuẩn mang gene chuyển
Vi khuẩn A. tumefaciens mang gene chuyển
Chuyển vector vào tế bào thực vật bằng A. tumefaciens và sàng lọc tế bào thực vật chuyển gene thành công
Đoạn T-DNA chứa gene đích đã cài vào NST cây trồng
Nuôi cấy tế bào
Tái sinh thành cây hoàn chỉnh mang gene chuyển
Cho đến nay, phương pháp sử dụng vi khuẩn A. tumefaciens để chuyển gene ở thực vật đã giúp tạo được nhiều giống cây trồng biển đổi gene (cây GMO). Tuy nhiên, do plasmid Ti thường chỉ lây nhiễm hiệu quả ở nhóm cây hai lá mầm (như bông, cà chua, khoai tây, các cây họ Đậu), trong khi lây nhiễm yếu ở nhóm cây một lá mầm – nhóm có nhiều loài cây lương thực quan trọng (như lúa, ngô), nền các nhà khoa học đã phát triển một số phương pháp để nâng cao hiệu quả chuyển gene ở các cây một lá mầm, trong số đó có phương pháp sử dụng “xung điện” và “súng bắn gene. Vì quá trình chuyển gene cần phải đưa được đoạn DNA đích vào trong nhân tế bào, nên các phương pháp này giúp phân tử DNA có thể xâm nhập vào nhân. Nguyên lí ứng dụng của phương pháp “xung điện" để chuyển gene ở thực vật về cơ bản cũng giống như ở vi khuẩn E. coli (xem mục II.3). Phương pháp "súng bắn gene" được Sanford phát triển năm 1988. Trong phương pháp này, "súng bắn gene" dùng áp lực của dòng khí trơ (Helium) để đẩy các hạt kim loại siêu nhỏ (kích cỡ nano – micro) được bọc bởi các đoạn DNA mang gene, đàm xuyên qua thành và các lớp màng đi vào nhân. Khi đoạn DNA ngoại lai đã ở trong nhận thì sẽ có cơ hội để gene chuyển kết hợp vào hệ gene của tế bào chủ theo cơ chế tái tổ hợp. Nhờ các gene chỉ thị chọn lọc (như gene phát sáng tử đom đóm) được dung hợp cùng gene chuyển, người ta có thể nhận biết các tế bào đã được chuyển gene thành công. Từ các tế bào chuyển gene, sử dụng công nghệ nuôi cấy tế bào để tái sinh thành cây chuyển gene. Đến nay, công nghệ gene đã được áp dụng để tạo các giống cây trồng GMO mang các đặc tính ưu việt đa dạng khác nhau như:
- Cây trồng chống chịu các điều kiện bất lợi của môi trường (chịu hạn, chịu lạnh, chịu mặn, chịu nhiệt).
- Giảm sử dụng thuốc trừ sâu hoá học (cây trồng kháng sâu).
- Giảm chi phí sau thu hoạch (gene chín chậm, gene kháng mọt).
- Tăng hiệu quả hấp thụ khoáng của cây (hạn chế gây xói mòn đất và bón phân).
Trang 25
- Tăng giá trị dinh dưỡng của cây trồng (ví dụ: giống lúa vàng mang gene quy định β - carotene là tiền chất của vitamin A)
Ngoài các ứng dụng trên, cây trồng GMO còn được sử dụng tạo ra nguyên liệu trong công nghiệp như một số dạng tinh bột dùng làm tá dược hay để sản xuất xăng sinh học.
Một ví dụ điển hình khác về ứng dụng công nghệ gene ở thực vật là nhóm các giống cây trồng được chuyển gene Bt kháng sâu, giúp giảm thiểu việc sử dụng thuốc trừ sâu, vừa
hạ giá thành sản xuất vừa bảo vệ môi trường và người sản xuất. Protein độc tố Bt vốn chỉ được tạo ra trong tự nhiên bởi vi khuẩn Bacillus thuringiensis (viết tắt là Bt). Gene độc
tố Bt được phân lập từ vi khuẩn và được chuyển vào thực vật bằng các phương pháp nhờ A. tumefaciens và súng bắn gene. Đến nay, nhiều giống cây trống GMO có khả năng tự
sản sinh ra "thuốc trừ sâu sinh học" đã được tạo ra, gồm các giống bông (H 3.7), ngô, lúa, cà chua, khoai tây và đậu tương Bt. Nhờ vậy, người trồng không phải sử dung thuốc trừ sâu trong suốt quá tình trồng trọt và thu hái.

Hình 3.7. Bông chuyển gene Bt kháng sâu bệnh (phải) so với bông không chuyển gene mẫn cảm sâu bệnh (trái)
2. Chuyển gene ở động vật
Chuyển gene ở các tế bào động vật và người nhằm hai mục đích chính: (1) Tạo ra các tế bào có gene được chỉnh sửa như thay thế gene bệnh bằng gene lành, làm bất hoạt hay hoạt hoá gene rồi đưa trở lại cơ thể như trong liệu pháp gene chữa bệnh di truyền và (2) tạo ra sinh vật chuyển gene hay sinh vật biến đổi gen có các đặc tính mong muốn để nghiên cứu hoặc ứng dụng trong thực tế.
Để tạo ra các tế bào chuyển gene, người ta thường sử dụng các tế bào động vật nuôi cấy rồi cho biến nạp DNA tái tổ hợp vào trong tế bào. Vector dùng để chuyển gene cho tế bào động vật thường là các loại retrovirus. Những loại retrovirus hay lây nhiễm các tế bào động vật được sử dụng làm vector vì chúng có sẵn khả nâng xâm nhập vào tế bào động vật nhờ các thụ thể đặc hiệu. Ngoài ra, khi vật chất di truyền của virus xâm nhập vào tế bào chúng được phiên mã ngược thành DNA và ích hợp vào hệ gene của tế bào chủ. Các nhà khoa học cần loại bỏ phần lớn các gene của virus, chỉ giữ lại những gene cần thiết cho quá trình tải nạp và tích hợp gene chuyển vào nhiễm sắc thể của tế bào.
Để tạo động vật chuyển gene thì vector mang gene chuyển cần phải được đưa vào tế bào trứng vừa được thụ tinh. Sau đó, hợp tử được nuôi cấy cho phát triển thành phôi sớm rồi cấy vào tử cùng của con vật để sinh ra con vật chuyển gene. Vector mang gene chuyển thường được tiêm vào trứng bằng vi kim tiêm hoặc nhờ virus (H 3.8)
Trang 26

Hình 3.8. Tạo động vật chuyển gene nhằm xác định chức năng của gene
A. Chuyển gene bằng vector virus
Virus mất gene gây bệnh làm vector
Tế bào soma hoặc tế bào mầm sinh dục của động vật
Vector virus cài gene đích vào tế bào tạo tế bào chuyển gene
Chuyển tế bào chuyển gene vào động vật
Sàng lọc động vật chuyển gene (có gene được cài vào hệ gene và biểu hiện đặc điểm mong muốn)
B. Chuyển gene bằng vi tiêm
Chủng vi khuẩn nhân dòng gene đích
Trứng thụ tinh trước khi dung hợp nhân (của trứng và tinh trùng)
Tinh sạch vector mang gene đích
Vi tiêm gene đích vào một trong hai nhân
Chuyển tế bào trứng đã chuyển gene vào động vật
Động vật chuyển gene được cho giao phối để duy trì chủng tái tổ hợp
Chuột, thỏ, lợn, cừu, bò và cá chuyển gene đã được tạo ra nhờ công nghệ gene (trong đó trên 95% động vật chuyển gene là chuột) để phục vụ cho các mục đích nghiên cứu như:
- Xác định chức năng gene: Khi giải trình tự hệ gene người, các nhà khoa học có thể nhận biết được một đoạn DNA nào đó là một gene nhưng không biết gene đó có chức năng gì.
Trang 27
Một trong các biện pháp xác định chức năng của gene trong trường hợp này là sử dụng kĩ thuật chuyển gene. Gene cần xác định chức năng được làm hỏng (thay đổi cấu trúc) rồi gắn vào vector, sau đó chuyển vào hợp tử của chuột, tạo ra sinh vật chuyển gene (H 3.8). Tế bào phôi chuột chuyển gene gia nhập vào phôi chuột và tạo nên các mô, ở đó gene chuyển bị mất chức năng có thể biểu hiện ra kiểu hình đột biến, nhờ vậy người ta có thể biết được chức năng của gene. Công trình nghiên cứu xác định chức năng của gene như vậy đã được trao giải thưởng Nobel Y học.
- Nghiên cứu bệnh học: Nhiều động vật chuyển gene được tạo ra nhằm giúp con người tìm hiểu cơ chế gây bệnh của các gene, cách các gene đóng góp vào quá trình phát sinh và tiến triển của bệnh. Các động vật chuyển gene như vậy được xem là mô hình bệnh của người, qua đó các nghiên cứu phát triển thuốc và phương pháp điều trị mới có thể thực hiện được. Động vật chuyển gene hiện là mô hình nghiên cứu bệnh lí của nhiều căn bệnh phức tạp như ung thư, hoá xơ nang, viêm khớp dạng thấp và Alzheimer.
- Sản xuất chế phẩm hoặc thuốc sinh học: Thuốc điều trị bệnh có bản chất hoặc thành phần chính là các đại phân tử sinh học (DNA, RNA, protein) được gọi là "thuốc sinh học". Cơ chế gây bệnh ở cấp phân tử của nhiều bệnh lí phức tạp ở người được công nghệ sinh học phân tử tìm ra gần đây đã khiến các thuốc sinh học ngày càng được ứng dụng rộng rãi nhờ có tính hướng đích và hiệu quả cao. Tuy vậy, giá thành thuốc thường đắt do chi phí sản xuất cao. Động vật chuyển gene đã giúp sản xuất các thuốc sinh học cho người bằng cách chuyển một phần hoặc toàn bộ DNA (gene) mã hoá sản phẩm protein của người. Chẳng hạn như gene α-1-antitrypsin người để điều trị bệnh phổi tắc nghẽn mạn tính (COPD) hoặc các thuốc được sản xuất theo nguyên lí tương tự cho điều trị bệnh phenyl keto niệu (PKU) và hoá xơ nang. Năm 1997 ghi dấu ấn ra đời "Rosie", con bò chuyển gene sản xuất sữa giàu protein người đầu tiên (mỗi lít sữa chứa 2,4 g protein người). Sữa bò chứa α-lactalbumin người được coi là sản phẩm cân bằng dinh dưỡng đối với trẻ sơ sinh hơn so với sữa bò tự nhiên.
- Mô hình thử nghiệm thuốc và vaccine: Chuột chuyển gene hiện nay được sử dụng ngày càng rộng rãi trong các nghiên cứu thử nghiệm về tính an toàn của thuốc và vaccine mới trước khi được thử nghiệm ở người. Kết quả nghiên cứu hệ gene học so sánh giữa người và các loài động vật có vú cùng các bằng chứng khác cho thấy mức tương đồng ở cấp phân tử giữa người và chuột cao hơn so với các dự đoán trước kia. Khi bằng chứng phân tử đủ tin cậy, chuột chuyển gene có thể được sử dụng thay thế cho khỉ trong các nghiên cứu về an toàn thuốc và vaccine mới, giúp rút ngắn thời gian, chi phí phát triển thuốc và vaccine.
| DỪNG LẠI VÀ SUY NGẪM Vì sao phải sử dụng vector khi chuyển gene từ tế bào này sang tế bào khác? Hãy sưu tầm các tài liệu về vi khuẩn chuyển gene có khả năng làm sạch các chất gây ô nhiễm môi trường như dầu mỏ, túi nylon,... |
Trang 28
| KIẾN THỨC CỐT LÕI - Công nghệ gene cho phép chuyển gene (DNA) trực tiếp từ cơ thể cho gene sang cơ thể nhận gene, đặc biệt, có thể chuyển gene từ loài này sang loài khác. Quy trình chuyển gene thường gồm ba bước: phân lập gene chuyển (gene ngoại lai) từ cơ thể cho, cài gene chuyển vào vector (tạo vector tái tổ hợp), đưa vector chuyển gene vào cơ thể nhận. - Vector là công cụ của công nghệ gene, giúp vận chuyển và gắn kết gene chuyển vào DNA hệ gene của tế bào nhận. Có nhiều loại vector khác nhau về nguồn gốc (vi khuẩn, virus, nấm men), trong đó vector plasmid của vi khuẩn là phổ biến nhất. Tuỳ thuộc kích thước DNA chuyển và loại tế bào nhận, để lựa chọn loại vector phù hợp. Mọi vector đều có ba thuộc tính: có trình tự khởi đầu tái bản, có gene chỉ thị chọn lọc và vị trí đa nhân dòng (vị trí cài gene). - Chuyển gene ở thực vật và động vật giống nhau về nguyên lí nhưng khác nhau về công cụ, phương pháp và mục đích ứng dụng. Vector chuyển gene thực vật hiệu quả là plasmid Ti có trong vi khuẩn Agrobacterium tumefaciens. Vector chuyển gene động vật hiệu quả thưởng có nguồn gốc virus. Cây trồng biến đổi gene được dùng nhiều cho mục dịch sản xuất nông nghiệp, trong khi động vật chuyển gene được dùng nhiều cho mục đích nghiên cứu, dinh dưỡng trị liệu và y tế (trong đó có liệu pháp gene chữa trị bệnh di truyền ở người). |
LUYỆN TẬP VÀ VẬN DỤNG
1. Việc sử dụng cây GMO và động vật chuyển gene trong thực tiến có thể mang lại các lợi ích và rủi ro gì so với các cây trồng và vật nuôi truyền thống?
2. Tại sao độc tố Bt có nguồn gốc vi khuẩn Baccillus thurigiensis được cây GMO tạo ra làm chết côn trùng (sâu bệnh) khi chúng ăn phải nhưng lại không gây độc cho chính vi khuẩn và cây GMO?
3. Dựa vào kiến thức đã học, hãy trình bày quy trình các bước cần phải làm để tạo ra được vi khuẩn chuyển gene có thể sản sinh ra hormone sinh trưởng của người (HGH).
Em có biết
Trong việc đẩy lùi đại dịch Covid–19 do virus viêm đường hô hấp SARS-CoV–2 gây ra trên khắp thế giới (giai đoạn 2019 – 2022), các vaccine của Pfizer/BioNTech và Moderna là những vaccine RNA đầu tiên được cấp phép sử dụng. Không giống vaccine truyền thống, vaccine RNA mang trình tự mRNA (đã được biến đổi hoả học một số nucleotide nhằm làm tăng tính bền của RNA) mã hoá cho các kháng nguyên đặc trưng của virus gây bệnh được đưa thẳng vào cơ thể. Chính các tế bào của cơ thể trở thành "nhà máy sản xuất protein kháng nguyên của virus" và hoạt hoá hệ miễn dịch chống lại virus gây bệnh. Các bằng chứng tới nay cho thấy, vaccine RNA được chế tạo nhanh hơn, giá thành rẻ hơn so với các vaccine truyền thống. Đây là một thành tựu mới của công nghệ gene.
Bình Luận
Để Lại Bình Luận Của Bạn